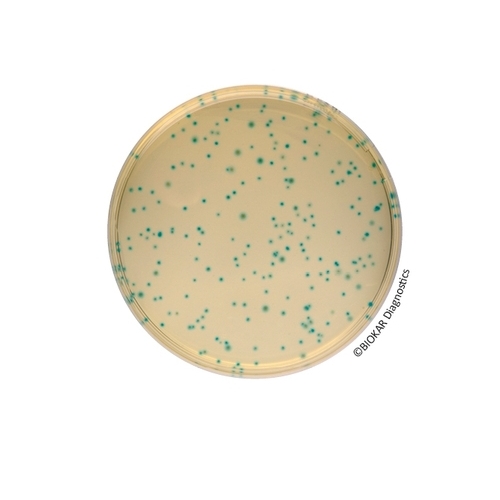
COMPASS® Bacillus Cereus Agar

COMPASS® Bacillus Cereus Agar
COMPASS® Bacillus cereus Agar is a solid medium used for the detection and the enumeration of spores and vegetative forms of presumptive species belonging to the group Bacillus cereus in products destined for human and animal consumption.
Detection or enumeration can be performed directly on this medium without purification steps, biochemical confirmation (glucose fermentation, Voges-Proskauer, nitrate reduction and hemolysis testing) and/or microscopic examination normally done within the confines of standardized methods. COMPASS® Bacillus cereus Agar for the enumeration of presumptive Bacillus cereus is officially certified by AFNOR Certification, under the reference number BKR 23/06-02/10.
| Ürün Adı | COMPASS® Bacillus Cereus Agar |
| Ürün Kodu | BK189HA |
| Miktar | 500 g |
| Ürün Adı | COMPASS® Bacillus Cereus Agar Selective Supplement |
| Ürün Kodu | BS06908 |
| Miktar | 10 vials qsp 100 mL |
| Ürün Adı | COMPASS® Bacillus Cereus Selective Supplement |
| Ürün Kodu | BS08508 |
| Miktar | 10 vials qsp 500 mL |
| Ürün Adı | COMPASS® Bacillus Cereus Agar |
| Ürün Kodu | BM12608 |
| Miktar | 20 Petri plates Ø 90 mm |
| Ürün Adı | COMPASS® Bacillus Cereus Agar |
| Ürün Kodu | BM13008 |
| Miktar | 10 vials of 100 mL |